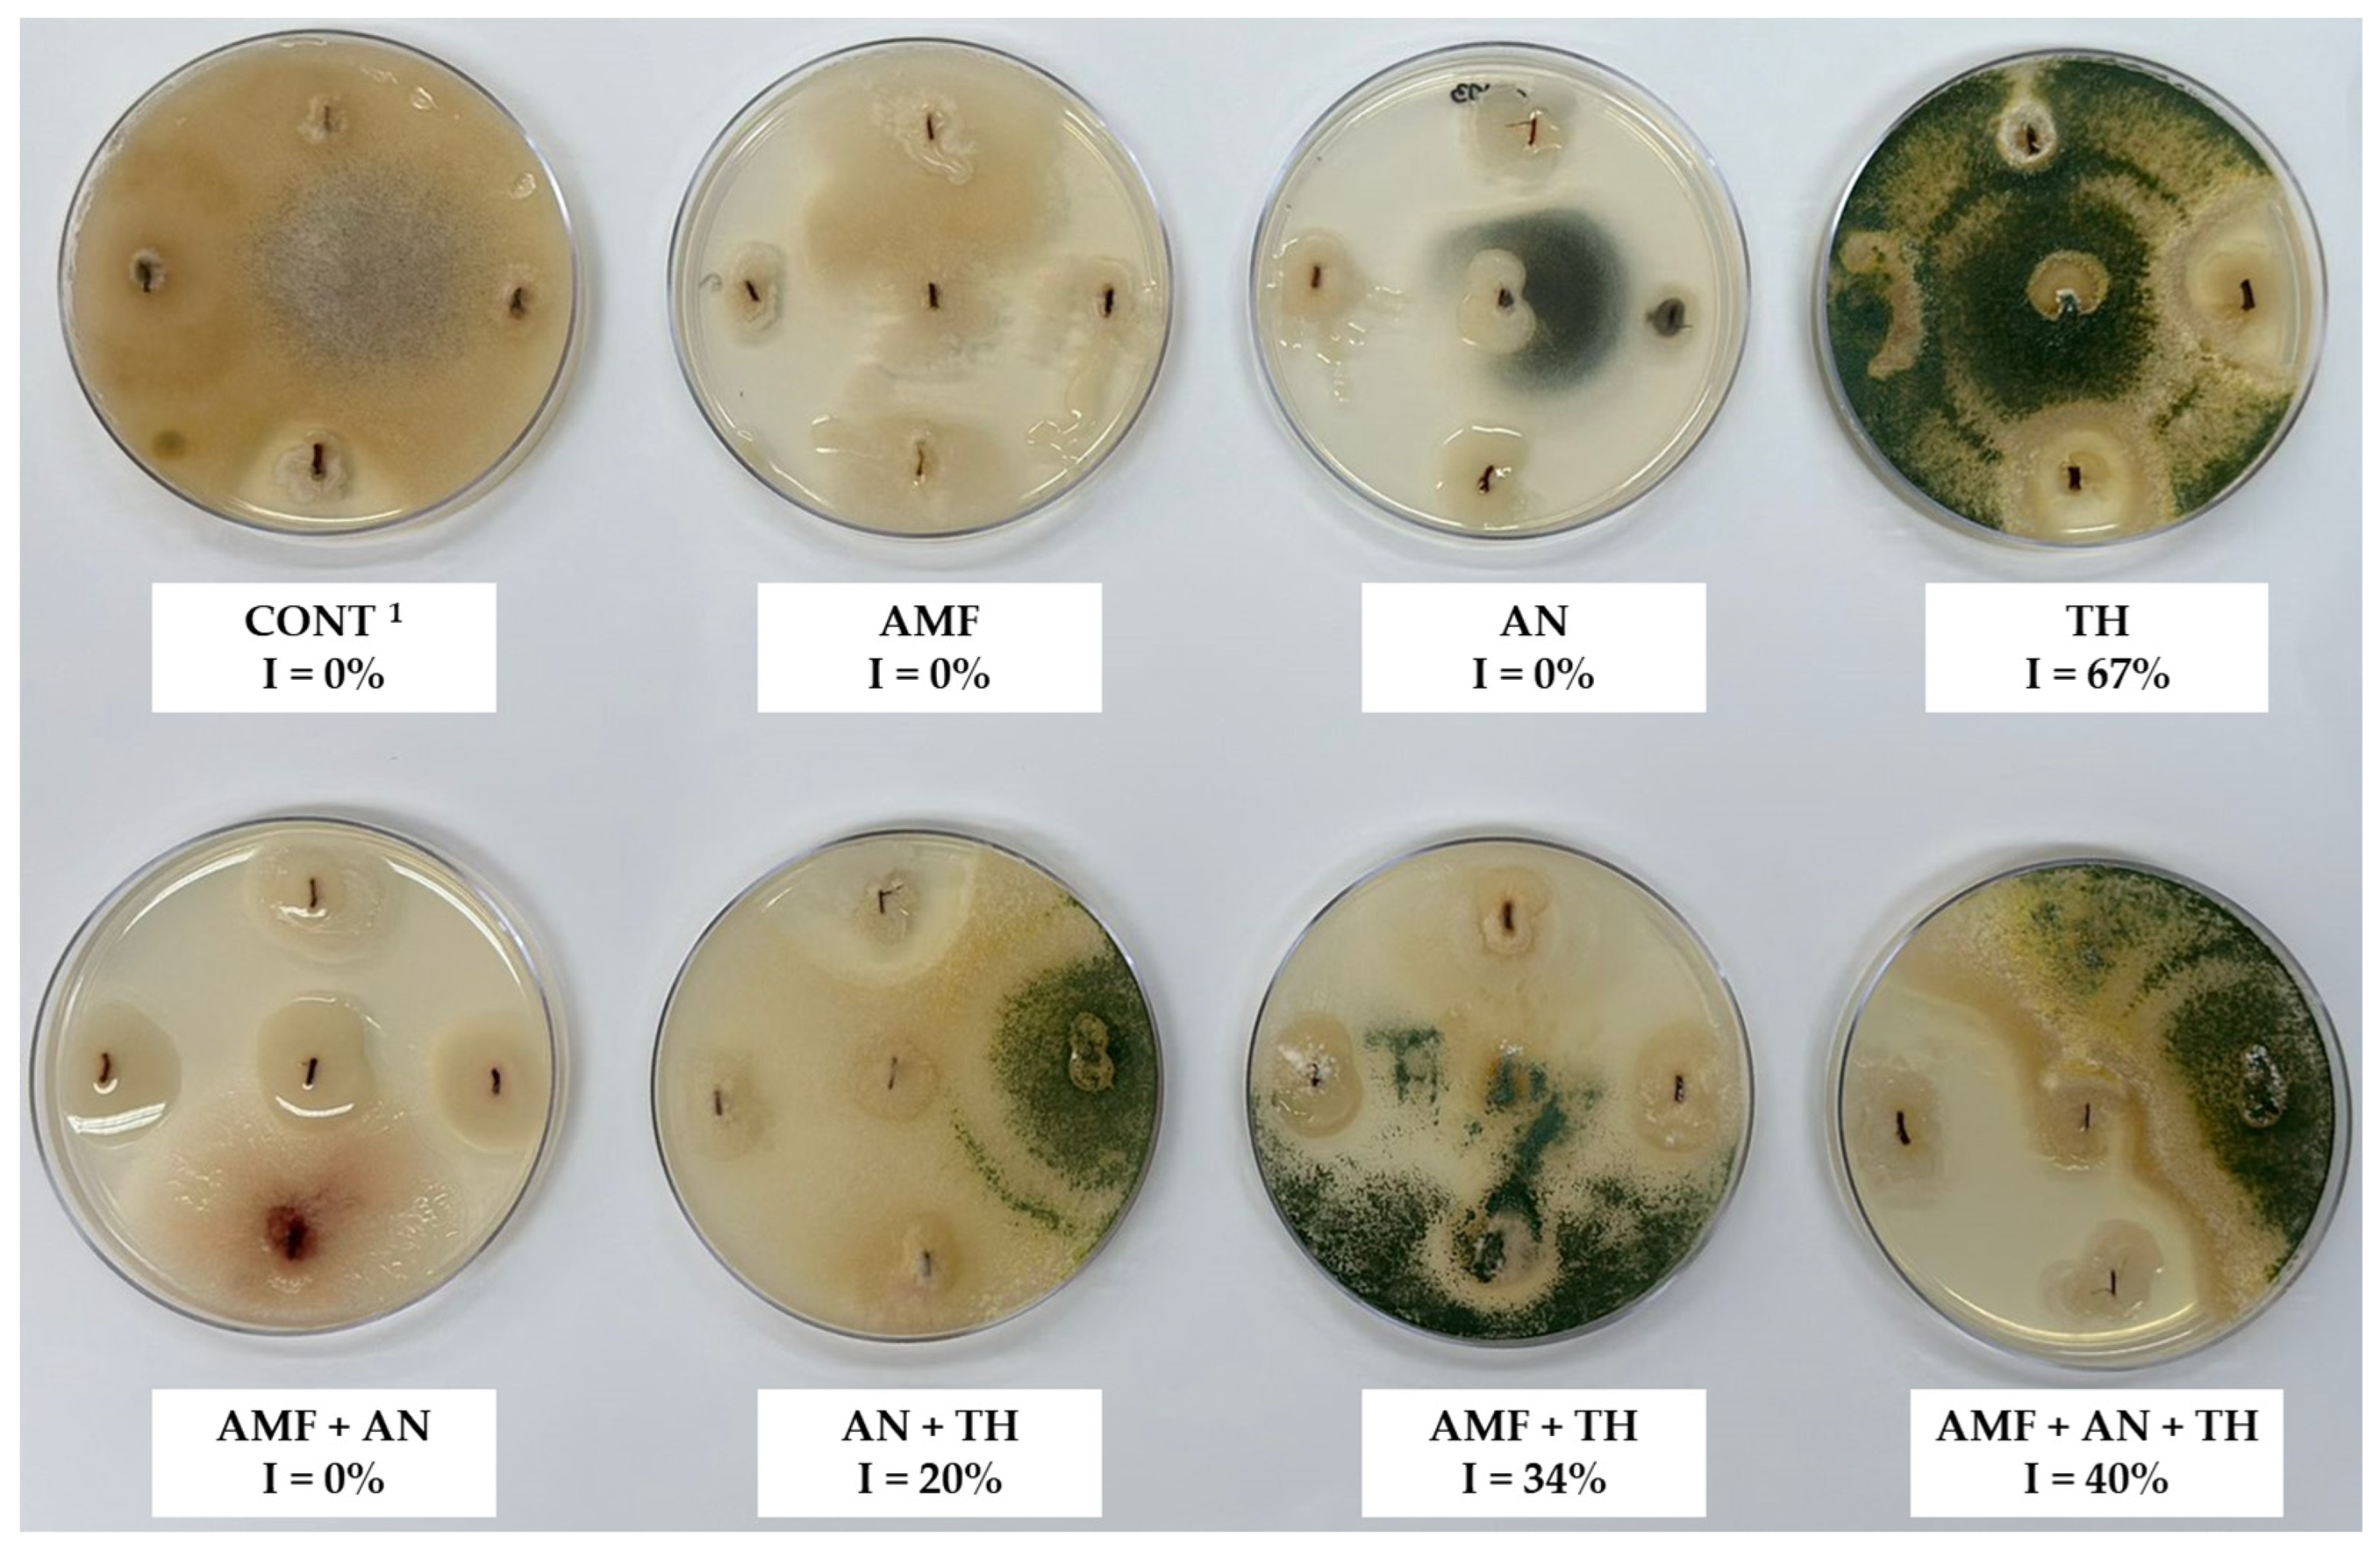
Agronomy 14 00860 g005 Agronomy 14 00860 g005

Arbuscular Mycorrhizal Fungi, Ascophyllum nodosum, Trichoderma harzianum, and Their Combinations Influence the Phyllochron, Phenology, and Fruit Quality of Strawberry Plants
Abstract
1. Introduction
2. Materials and Methods
2.1. Plant Material
2.2. Experimental Design
2.3. Procedures
2.4. Mycorrhizal Colonization
2.5. Trichoderma–Plant Root Detection
2.6. Phyllochron
2.7. Phenology
2.8. Fruit Quality
2.9. Data Analysis
3. Results
3.1. Mycorrhizal Colonization
3.2. Trichoderma–Plant Root Detection
3.3. Phyllochron
3.4. Phenology
3.5. Fruit Quality
4. Discussion
5. Conclusions
Author Contributions
Funding
Data Availability Statement
Acknowledgments
Conflicts of Interest
References
- Alves, M.C.; Matoso, E.S.; Peil, R.M.N. What is the profile of strawberry producers in the south Brazilian region and what do they think about substrate cultivation? Hortic. Bras. 2020, 38, 428–433. [Google Scholar] [CrossRef]
- Chiomento, J.L.T.; De Nardi, F.S.; Kujawa, S.C.; Deggerone, Y.S.; Fante, R.; Kaspary, I.J.; Dornelles, A.G.; Huzar-Novakowiski, J.; Trentin, T.S. Multivariate contrasts of seven strawberry cultivars in soilless cultivation and greenhouse in southern Brazil. Adv. Chem. Res. 2023, 2, 62–76. [Google Scholar] [CrossRef]
- Ho-Plágaro, T.; García-Garrido, J.M. Molecular regulation of arbuscular mycorrhizal symbiosis. Int. J. Mol. Sci. 2022, 23, 5960. [Google Scholar] [CrossRef] [PubMed]
- Chiomento, J.L.T.; De Nardi, F.S.; Filippi, D.; Trentin, T.S.; Dornelles, A.G.; Fornari, M.; Nienow, A.A.; Calvete, E.O. Morpho-horticultural performance of strawberry cultivated on substrate with arbuscular mycorrhizal fungi and biochar. Sci. Hortic. 2021, 282, 110053. [Google Scholar] [CrossRef]
- Trentin, T.S.; Dornelles, A.G.; Trentin, N.S.; Huzar-Novakowiski, J.; Calvete, E.O.; Chiomento, J.L.T. Addition of arbuscular mycorrhizal fungi and biochar in the cultivation substrate benefits macronutrient contents in strawberry plants. J. Soil. Sci. Plant Nutr. 2022, 22, 2980–2991. [Google Scholar] [CrossRef]
- Chiomento, J.L.T.; De Nardi, F.S.; Filippi, D.; Trentin, T.S.; Anzolin, A.P.; Bertol, C.D.; Nienow, A.A.; Calvete, E.O. Mycorrhization of strawberry plantlets potentiates the synthesis of phytochemicals during ex vitro acclimatization. Acta Sci. Agron. 2022, 44, 55682. [Google Scholar] [CrossRef]
- Tajdinian, S.; Rahmati-Joneidabad, M.; Ghodoum Parizipour, M.H. Macroalgal treatment to alleviate the strawberry yield loss caused by Macrophomina phaseolina (Tassi) Goid. in greenhouse cultivation system. Front. Sustain. Food Syst. 2022, 6, 1089553. [Google Scholar] [CrossRef]
- El-Sheekh, M.M.; Ahmed, A.Y.; Soliman, A.S.; Abdel-Ghafour, S.E.; Sobhy, H.M. Biological control of soil borne cucumber diseases using green marine macroalgae. Egypt. J. Biol. Pest. Control 2021, 31, 72. [Google Scholar] [CrossRef]
- Mostafa, Y.S.; Alamri, S.A.; Alrumman, S.A.; Hashem, M.; Taher, M.A.; Baka, Z.A. In vitro and in vivo biocontrol of tomato Fusarium wilt by extracts from brown, red, and green macroalgae. Agriculture 2022, 12, 345. [Google Scholar] [CrossRef]
- Patel, J.S.; Selvaraj, V.; More, P.; Bahmani, R.; Borza, T.; Prithiviraj, B. A plant biostimulant from Ascophyllum nodosum potentiates plant growth promotion and stress protection activity of Pseudomonas protegens CHA0. Plants 2023, 12, 1208. [Google Scholar] [CrossRef]
- Alam, M.Z.; Brown, G.; Norrie, J.; Hodges, D.M. Effect of Ascophyllum extract application on plant growth, fruit yield and soil microbial communities of strawberry. Can. J. Plant Sci. 2013, 93, 23–36. [Google Scholar] [CrossRef]
- El-Miniawy, S.M.; Ragab, M.E.; Youssef, S.M.; Metwally, A.A. Influence of foliar spraying of seaweed extract on growth, yield and quality of strawberry plants. J. Appl. Sci. Res. 2014, 10, 88–94. [Google Scholar]
- Bajpai, S.; Shukla, P.S.; Asiedu, S.; Pruski, K.; Prithiviraj, B. A biostimulant preparation of brown seaweed Ascophyllum nodosum suppresses powdery mildew of strawberry. Plant Pathol. J. 2019, 35, 406–416. [Google Scholar] [CrossRef] [PubMed]
- Woo, S.L.; Hermosa, R.; Lorito, M.; Monte, E. Trichoderma: A multipurpose, plant-beneficial microorganism for eco-sustainable agriculture. Nat. Rev. Microbiol. 2023, 21, 312–326. [Google Scholar] [CrossRef] [PubMed]
- Mercado, J.A.; Barceló, M.; Pliego, C.; Rey, M.; Caballero, J.L.; Muñoz-Blanco, J.; Ruano-Rosa, D.; López-Herrera, C.; Santos, B.; Romero-Muñoz, F.; et al. Expression of the β-1,3-glucanase gene bgn13.1 from Trichoderma harzianum in strawberry increases tolerance to crown rot diseases but interferes with plant growth. Transgenic Res. 2015, 24, 979–989. [Google Scholar] [CrossRef] [PubMed]
- Lombardi, N.; Caira, S.; Troise, A.D.; Scaloni, A.; Vitaglione, P.; Vinale, F.; Marra, R.; Salzano, A.M.; Lorito, M.; Woo, S.L. Trichoderma applications on strawberry plants modulate the physiological processes positively affecting fruit production and quality. Front. Microbiol. 2020, 11, 1364. [Google Scholar] [CrossRef] [PubMed]
- Lopes-da-Silva, F.; Escribano-Bailon, M.T.; Alonso, J.J.P.; Rivas-Gonzalo, J.C.; Santos-Buelga, C. Anthocyanin pigments in strawberry. LWT Food Sci. Technol. 2007, 40, 374–382. [Google Scholar] [CrossRef]
- Xue, Q.; Weiss, A.; Baenziger, P.S. Predicting leaf appearance in field-grown winter wheat: Evaluating linear and non-linear models. Ecol. Modell. 2004, 175, 261–270. [Google Scholar] [CrossRef]
- Chiomento, J.L.T.; Stürmer, S.L.; Carrenho, R.; Costa, R.C.; Scheffer-Basso, S.M.; Antunes, L.E.C.; Nienow, A.A.; Calvete, E.O. Composition of arbuscular mycorrhizal fungi communities signals generalist species in soils cultivated with strawberry. Sci. Hortic. 2019, 253, 286–294. [Google Scholar] [CrossRef]
- Redecker, D.; Schubler, A.; Stockinger, H.; Stürmer, S.L.; Morton, J.B.; Walker, C. An evidence based consensus for the classification of arbuscular mycorrhizal fungi (Glomeromycota). Mycorrhiza 2013, 23, 515–531. [Google Scholar] [CrossRef]
- Stutz, J.C.; Morton, J.B. Successive pot culture reaveal high species richness of arbuscular endomycorrhizal fungi in arid ecosystems. Can. J. Bot. 1996, 74, 1883–1889. [Google Scholar] [CrossRef]
- Furlani, P.R.; Fernandes Júnior, F. Cultivo Hidropônico de Morango em Ambiente Protegido; Embrapa: Curitiba, Brasil, 2004; pp. 102–115. [Google Scholar]
- De Nardi, F.S.; Trentin, T.S.; Trentin, N.S.; Costa, R.C.; Calvete, E.O.; Palencia, P.; Chiomento, J.L.T. Mycorrhizal biotechnology reduce phosphorus in the nutrient solution of strawberry soilless cultivation systems. Agronomy 2024, 14, 355. [Google Scholar] [CrossRef]
- Phillips, J.M.; Hayman, D.S. Improved procedures for clearing roots and staining parasitic and vesicular-arbuscular mycorrhizal fungi for rapid assessment of infection. Trans. Br. Mycol. Soc. 1970, 55, 158–161. [Google Scholar] [CrossRef]
- Trouvelot, A.; Kouch, J.; Gianinazzi-Pearson, V. Mesure du taux de mycorhization VA d’un système radiculaire: Recherche of method d’estimation ayant une signification fonctionelle. In Aspects Physiologiques et Génétiques des Mycorhizes; Gianinazzi-Pearson, V., Gianinazzi, S., Eds.; Inra Press: Paris, France, 1986; pp. 217–221. [Google Scholar]
- Fernandez, M.R. Manual Para Laboratório de Fitopatologia; Embrapa: Passo Fundo, Brasil, 1993; p. 128. [Google Scholar]
- Deggerone, Y.S.; Trentin, T.S.; Kujawa, S.C.; Albrecht, G.E.; Fante, R.; Kaspary, I.J.; Fornari, M.; Chiomento, J.L.T. Phenology and phyllochron of seven strawberry cultivars grown in substrate and greenhouse in the Brazilian subtropics. Comun. Sci. 2023, 14, 4054. [Google Scholar] [CrossRef]
- Antunes, O.T.; Calvete, E.O.; Rocha, H.C.; Nienow, A.A.; Mariani, F.; Wesp, C.L. Floração, frutificação e maturação de frutos de morangueiro cultivados em ambiente protegido. Hortic. Bras. 2006, 24, 426–430. [Google Scholar] [CrossRef]
- Gilmore Junior, E.C.; Rogers, J.S. Heat units as a method of measuring maturity in corn. Agron. J. 1958, 50, 611–615. [Google Scholar] [CrossRef]
- Arnold, C.Y. Maximum-minimum temperature as a basis for computing heat units. J. Am. Soc. Hortic. Sci. 1960, 76, 682–692. [Google Scholar]
- Klepper, B.; Rickman, R.W.; Peterson, C.M. Quantitative characterization of vegetative development in small cereal grains. Agron. J. 1982, 7, 780–792. [Google Scholar]
- Kirby, E.J.M. Environmental factors influencing the phyllochron. Crop Sci. 1995, 35, 11–19. [Google Scholar] [CrossRef]
- Meier, U.; Graf, H.; Hack, M.; Hess, M.; Kennel, W.; Klose, R.; Mappes, D.; Seipp, D.; Stauss, R.; Streif, J.; et al. Phänologische entwicklungsstadien des kernobstes (Malus domestica Borkh. und Pyrus communis L.), des steinobstes (Prunus-Arten), der johannisbeere (Ribes-Arten) und der erdbeere (Fragaria × ananassa Duch.). Nachrichtenbl. Deut. Pflanzenschutzd. 1994, 46, 141–153. [Google Scholar]
- Zenebon, O.; Pascuet, N.S.; Tiglea, P. Métodos Físico-Químicos para Análise de Alimentos, 4th ed.; Instituto Adolfo Lutz: São Paulo, Brasil, 2008; p. 1020. [Google Scholar]
- CoHort Software. CoStat: Graphics and Statistics Software for Scientists and Engineers, CoHort Software: California, CA, USA, 2003.
- Cruz, C.D. Genes Software—Extended and Integrated with the R, Matlab and Selegen. Acta Sci. Agron. 2016, 38, 547–552. [Google Scholar] [CrossRef]
- Singh, D. The relative importance of characters affecting genetic divergence. Indian J. Genet. Plant Breed. 1981, 41, 237–245. [Google Scholar]
- Lucas, D.D.P.; Streck, N.A.; Bortoluzzi, M.P.; Trentin, R.; Maldaner, I.C. Temperatura base para emissão de nós e plastocrono de plantas de melancia. Rev. Ciênc. Agron. 2012, 43, 288–292. [Google Scholar] [CrossRef][Green Version]
- Schoffel, A.; Koefender, J.; Camera, J.; Golle, D.; Broch, J.; Mugnol, J.; Manfio, C. Transplanting seasons, phyllochron and production of strawberry cultivars in soil. Contrib. Las Cienc. Soc. 2023, 16, 8358–8374. [Google Scholar]
- Mendonça, H.F.C.; Calvete, E.O.; Nienow, A.A.; Costa, R.C.; Zerbielli, L.; Bonafé, M. Estimativa do filocrono de morangueiro em sistemas consorciado e solteiro em ambientes protegidos. Rev. Bras. Frutic. 2012, 4, 15–23. [Google Scholar] [CrossRef]
- Costa, R.C.; Calvete, E.O.; De Nardi, F.S.; Pedersen, A.C.; Chiomento, J.L.T.; Trentin, N.S. Quality of strawberry seedlings can determine precocity. Aust. J. Crop Sci. 2018, 2, 81–86. [Google Scholar] [CrossRef]
- Meier, U. Growth Stages of Mono- and Dicotyledonous Plants; Federal Biological Research Centre for Agriculture and Forestry: Berlin, Germany, 2001. [Google Scholar]
- Meier, U. Strawberry: Growth Stages of Plants; Blackwell Wissenschafts-Verlag: Berlin, Germany, 1997; pp. 62–64. [Google Scholar]
- Arcidiacono, M.; Pellegrino, E.; Nuti, M.; Ercoli, L. Field inoculation by arbuscular mycorrhizal fungi with contrasting life-history strategies differently affects tomato nutrient uptake and residue decomposition dynamics. Plant Soil. 2023, 1–23. [Google Scholar] [CrossRef]
- Stirk, W.A.; Rengasamy, K.R.R.; Kulkarni, M.G.; van Staden, J. Plant biostimulants from seaweed. In The Chemical Biology of Plant Biostimulants; Geelen, D., Xu, L., Eds.; John Wiley & Sons, Ltd.: Hoboken, NJ, USA, 2020; pp. 31–55. [Google Scholar]
- Khan, W.; Menon, U.; Subramanian, S.; Jithesh, M.; Rayorath, P.; Hodges, D.; Crithcley, A.; Craigie, J.; Norrie, J.; Prithiviraj, B. Seaweed extracts as biostimulants of plant growth and development. J. Plant Growth. Regul. 2009, 28, 386–399. [Google Scholar] [CrossRef]
- Espinosa-Antón, A.; Hernández-Herrera, R.; González, M. Extractos bioactivos de algas marinas como bioestimulantes del crecimiento y la protección de las plantas. Biot. Veg. 2020, 20, 257–282. [Google Scholar]
- Van Oosten, M.J.; Pepe, O.; De Pascale, S.; Silletti, S.; Maggio, A. The role of biostimulants and bioeffectors as alleviators of abiotic stress in crop plants. Chem. Biol. Technol. Agric. 2017, 4, 5. [Google Scholar] [CrossRef]
- De Saeger, J.; Van Praet, S.; Vereecke, D.; Park, J.; Jacques, S.; Han, T.; Depuydt, S. Toward the molecular understanding of the action mechanism of Ascophyllum nodosum extracts on plants. J. Appl. Phycol. 2020, 32, 573–597. [Google Scholar] [CrossRef]
- Vera, J.; Castro, J.; González, A.; Moenne, A. Seaweed polysaccharides and derived oligosaccharides stimulate defense responses and protection against pathogens in plants. Mar. Drugs 2011, 9, 2514–2525. [Google Scholar] [CrossRef] [PubMed]
- Craigie, J.S. Seaweed extract stimuli in plant science and agriculture. J. Appl. Phycol. 2011, 23, 371–393. [Google Scholar] [CrossRef]
- Yalçin, S.; Okudan, E.S.; Karakaș, O.; Önem, A.N.; Bașkan, K.S. Identification and quantification of some phytohormones in seaweeds using UPLC-MS/MS. J. Liq. Chromatogr. Relat. Technol. 2019, 42, 475–484. [Google Scholar] [CrossRef]
- Bona, E.; Lingua, G.; Manassero, P.; Cantamessa, S.; Marsano, F.; Todeschini, V.; Copetta, A.; D’Agostino, G.; Massa, N.; Avidano, L.; et al. AM fungi and PGP pseudomonads increase flowering, fruit production, and vitamin content in strawberry grown at low nitrogen and phosphorus levels. Mycorrhiza 2015, 25, 181–193. [Google Scholar] [CrossRef] [PubMed]
- Fraceto, L.F.; Maruyama, C.R.; Guilger, M.; Mishra, S.; Keswani, C.; Singh, H.B.; Lima, R. Trichoderma harzianum-based novel formulations: Potential applications for management of Next-Gen agricultural challenges. J. Chem. Technol. Biotechnol. 2018, 93, 2056–2063. [Google Scholar] [CrossRef]
- Cano, M.A. A review of interaction of beneficial microorganisms in plants: Mycorrhizae, Trichoderma spp. and Pseudomonas spp. Rev. UDC Actual. Divulg. Cient. 2011, 14, 15–31. [Google Scholar] [CrossRef]
- Cai, X.; Zhao, H.; Liang, C.; Li, M.; Liu, R. Effects and mechanisms of symbiotic microbial combination agents to control tomato Fusarium crown and root rot disease. Front. Microbiol. 2021, 12, 629793. [Google Scholar] [CrossRef] [PubMed]
- Wang, X.; Chen, M.; Yang, G.; Li, X.; Li, P.; Chen, M. Effect of Glomus versiforme and Trichodema harzianum on growth and quality of Salvia miltiorrhiza. Zhong Yao Cai 2014, 39, 1574–1578. [Google Scholar]
- Martínez-Medina, A.; Pascual, J.A.; Lloret, E.; Roldán, A. Interactions between arbuscular mycorrhizal fungi and Trichoderma harzianum and their effects on Fusarium wilt in melon plants grown in seedling nurseries. J. Sci. Food Agric. 2009, 89, 1843–1850. [Google Scholar] [CrossRef]
- Poveda, J.; Hermosa, R.; Monte, E.; Nicolás, C. Trichoderma harzianum favours the access of arbuscular mycorrhizal fungi to non-host Brassicaceae roots and increases plant productivity. Sci. Rep. 2019, 9, 11650. [Google Scholar] [CrossRef]
- Martínez-Medina, A.; Roldán, A.; Pascual, J.A. Interaction between arbuscular mycorrhizal fungi and Trichoderma harzianum under conventional and low input fertilization field condition in melon crops: Growth response and Fusarium wilt biocontrol. Appl. Soil Ecol. 2011, 47, 98–105. [Google Scholar] [CrossRef]
- Morán-Diez, E.; Rubio, B.; Domínguez, S.; Hermosa, R.; Monte, E.; Nicolás, C. Transcriptomic response of Arabidopsis thaliana after 24 h incubation with the biocontrol fungus Trichoderma harzianum. J. Plant Physiol. 2012, 169, 614–620. [Google Scholar] [CrossRef] [PubMed]
- Maillet, F.; Poinsot, V.; André, O.; Puech-Pagès, V.; Haouy, A.; Gueunier, M.; Cromer, L.; Giraudet, D.; Formey, D.; Niebel, A.; et al. Fungal lipochitooligosaccharide symbiotic signals in arbuscular mycorrhiza. Nature 2011, 469, 58–63. [Google Scholar] [CrossRef]
- Mendoza-Mendoza, A.; Zaid, R.; Lawry, R.; Hermosa, R.; Monte, E.; Horwitz, B.A.; Mukherjee, P.K. Molecular dialogues between Trichoderma and roots: Role of the fungal secretome. Fungal Biol. Rev. 2018, 32, 62–85. [Google Scholar] [CrossRef]
- Hause, B.; Maier, W.; Miersch, O.; Kramell, R.; Strack, D. Induction of jasmonate biosynthesis in arbuscular mycorrhizal barley roots. Plant Physiol. 2002, 130, 1213–1220. [Google Scholar] [CrossRef]
- El-Sharkawy, H.H.A.; Rashad, Y.M.; Ibrahim, S.A. Biocontrol of stem rust disease of wheat using arbuscular mycorrhizal fungi and Trichoderma spp. Physiol. Mol. Plant Pathol. 2018, 103, 84–91. [Google Scholar] [CrossRef]
- Rouphael, Y.; Franken, P.; Schneider, C.; Schwarz, D.; Giovannetti, M.; Agnolucci, M.; De Pascale, S.; Bonini, P.; Colla, G. Arbuscular mycorrhizal fungi act as biostimulants in horticultural crops. Sci. Hortic. 2015, 196, 91–108. [Google Scholar] [CrossRef]
- López-Bucio, J.; Pelagio-Flores, R.; Herrera-Estrella, A. Trichoderma as biostimulant: Exploiting the multilevel properties of a plant beneficial fungus. Sci. Hortic. 2015, 196, 109–123. [Google Scholar] [CrossRef]
- Rouphael, Y.; Colla, G. Synergistic Biostimulatory action: Designing the next generation of plant biostimulants for sustainable agriculture. Front. Plant Sci. 2018, 9, 1655. [Google Scholar] [CrossRef]
- Formisano, L.; Miras-Moreno, B.; Ciriello, M.; El-Nakhel, C.; Corrado, G.; Lucini, L.; Colla, G.; Rouphael, Y. Trichoderma and phosphite elicited distinctive secondary metabolite signatures in zucchini squash plants. Agronomy 2021, 11, 1205. [Google Scholar] [CrossRef]
- Bonini, P.; Rouphael, Y.; Miras-Moreno, B.; Lee, B.; Cardarelli, M.; Erice, G.; Cirino, V.; Lucini, L.; Colla, G. A Microbial-based biostimulant enhances sweet pepper performance by metabolic reprogramming of phytohormone profile and secondary metabolism. Front. Plant Sci. 2020, 11, 567388. [Google Scholar] [CrossRef] [PubMed]
- Nanjundappa, A.; Bagyaraj, D.J.; Saxena, A.K.; Kumar, M.; Chakdar, H. Interaction between arbuscular mycorrhizal fungi and Bacillus spp. in soil enhancing growth of crop plants. Fungal Biol. Biotechnol. 2019, 6, 23. [Google Scholar] [CrossRef]
- Thejaswini, H.P.; Shivakumar, B.S.; Sarvajna, B.S.; Ganapathi, M.; Yallesh, H.S.K. Studies on split application of NPK fertilizers and liquid bio-formulation (Jeevamrutha) on yield and quality of pomegranate (Punica granatum L.) in central dry zone of Karnataka. Pharm. Innov. 2022, 11, 494–498. [Google Scholar]
- Salem, A.; Khandaker, M.M.; Mahmud, K.; Alsufyani, S.J.; Majrashi, A.A.; Rashid, Z.M.; Alenazi, M.M.; Osman, N.; Badaluddin, N.A. Enhancing photosynthesis and root development for better fruit quality, aroma, and lessening of radioactive materials in key lime (Citrus aurantifolia) using Trichoderma harzianum and Bacillus thuringiensis. Plant Physiol. Biochem. 2024, 206, 108295. [Google Scholar] [CrossRef] [PubMed]
- Islam, M.S.; Jalaluddin, M.; Garner, J.O.; Yoshimoto, M.; Yamakawa, O. Artificial shading and temperature influence on anthocyanin compositions in sweetpotato leaves. HortScience 2005, 40, 176–180. [Google Scholar] [CrossRef]
- Chiomento, J.L.T.; Filippi, D.; Zanin, E.; Piuco, M.G.; Trentin, T.S.; Dornelles, A.G.; Fornari, M. Arbuscular mycorrhiza potentiates the quality of fruits but does not influence the precocity of goldenberry plants. Braz. J. Dev. 2020, 6, 79041–79056. [Google Scholar] [CrossRef]

| Physical characterization 1 | ||||||
| D | TP | AE | RAW | BW | RW | |
| (kg·m−3) | (m3·m−3) | |||||
| 212 | 0.885 | 0.502 | 0.144 | 0.017 | 0.222 | |
| Chemical characterization 2 | ||||||
| N | P2O5 | K2O | OC | pH | EC | C/N ratio |
| % (m·m−1) | mS·cm−1 | |||||
| 0.82 | 0.58 | <0.25 | 26.10 | 7.6 | 1.05 | 33.42 |
| Treatments 1 | Phyllochron (°C day·leaf−1) |
|---|---|
| CONT | 88.50 ± 21.94 cd |
| AMF | 144.93 ± 29.35 a |
| AN | 99.01 ± 28.93 c |
| TH | 86.96 ± 23.78 d |
| AMF + AN | 82.64 ± 20.62 d |
| AMF + TH | 77.52 ± 27.87 e |
| AN + TH | 103.09 ± 39.25 bc |
| AMF + AN + TH | 108.70 ± 36.42 b |
| Treatments 1 | T 2 | Stage 11 | Stage 55 | Stage 60 | Stage 71 | Stage 87 | TTF (Days) | TFH (Days) | TTH (Days) | ||||
|---|---|---|---|---|---|---|---|---|---|---|---|---|---|
| O (DAT) | D (Days) | O (DAT) | D (Days) | O (DAT) | D (Days) | O (DAT) | D (Days) | O (DAT) | |||||
| CONT | 21-June | 7 | 33 | 40 | 6 | 46 | 3 | 49 | 23 | 72 | 40 | 32 | 72 |
| AMF | 21-June | 12 | 28 | 40 | 10 | 50 | 4 | 54 | 21 | 75 | 40 | 35 | 75 |
| AN | 21-June | 12 | 23 | 35 | 4 | 39 | 3 | 42 | 30 | 72 | 35 | 37 | 72 |
| TH | 21-June | 12 | 23 | 35 | 4 | 39 | 3 | 42 | 23 | 65 | 35 | 30 | 65 |
| AMF + AN | 21-June | 12 | 25 | 37 | 2 | 39 | 3 | 42 | 30 | 72 | 37 | 35 | 72 |
| AMF + TH | 21-June | 12 | 23 | 35 | 9 | 44 | 3 | 47 | 14 | 61 | 35 | 26 | 61 |
| AN + TH | 21-June | 12 | 28 | 40 | 10 | 50 | 4 | 54 | 18 | 72 | 40 | 32 | 72 |
| AMF + AN + TH | 21-June | 12 | 28 | 40 | 7 | 47 | 9 | 56 | 16 | 72 | 40 | 32 | 72 |
| Phenological Stages | Sj | Sj (100%) |
|---|---|---|
| 11 | 175.0 | 3.5211 |
| 55 | 348.0 | 7.002 |
| 60 | 1276.0 | 25.674 |
| 71 | 1964.0 | 39.5171 |
| 87 | 1207.0 | 24.2857 |
| Treatments 1 | TSSs (%) 2 | TTA (% of Citric Acid) | TSS/TTA Ratio |
|---|---|---|---|
| CONT | 5.00 ± 1.25 | 0.94 ± 0.002 | 5.31 ± 1.27 c |
| AMF | 5.47 ± 1.39 | 0.68 ± 0.003 | 8.07 ± 1.74 ab |
| AN | 5.72 ± 1.35 | 0.72 ± 0.002 | 7.92 ± 1.56 ab |
| TH | 6.57 ± 1.76 | 0.80 ± 0.001 | 8.20 ± 1.82 ab |
| AMF + AN | 6.47 ± 1.14 | 0.75 ± 0.004 | 8.58 ± 1.05 ab |
| AMF + TH | 7.27 ± 1.07 | 0.72 ± 0.001 | 10.12 ± 1.91 a |
| AN + TH | 6.30 ± 1.42 | 0.80 ± 0.001 | 7.89 ± 1.53 ab |
| AMF + AN + TH | 5.95 ± 1.01 | 0.77 ± 0.003 | 7.74 ± 1.39 b |
| Significance | NS | NS | ** |
| Mean | 6.09 | 0.77 | 7.98 |
| CV (%) 3 | 12.81 | 12.64 | 10.09 |
Disclaimer/Publisher’s Note: The statements, opinions and data contained in all publications are solely those of the individual author(s) and contributor(s) and not of MDPI and/or the editor(s). MDPI and/or the editor(s) disclaim responsibility for any injury to people or property resulting from any ideas, methods, instructions or products referred to in the content. |
© 2024 by the authors. Licensee MDPI, Basel, Switzerland. This article is an open access article distributed under the terms and conditions of the Creative Commons Attribution (CC BY) license (https://creativecommons.org/licenses/by/4.0/).
Share and Cite
Chiomento, J.L.T.; Fracaro, J.; Görgen, M.; Fante, R.; Dal Pizzol, E.; Welter, M.; Klein, A.P.; Trentin, T.d.S.; Suzana-Milan, C.S.; Palencia, P. Arbuscular Mycorrhizal Fungi, Ascophyllum nodosum, Trichoderma harzianum, and Their Combinations Influence the Phyllochron, Phenology, and Fruit Quality of Strawberry Plants. Agronomy 2024, 14, 860. https://doi.org/10.3390/agronomy14040860
Chiomento JLT, Fracaro J, Görgen M, Fante R, Dal Pizzol E, Welter M, Klein AP, Trentin TdS, Suzana-Milan CS, Palencia P. Arbuscular Mycorrhizal Fungi, Ascophyllum nodosum, Trichoderma harzianum, and Their Combinations Influence the Phyllochron, Phenology, and Fruit Quality of Strawberry Plants. Agronomy. 2024; 14(4):860. https://doi.org/10.3390/agronomy14040860
Chicago/Turabian StyleChiomento, José Luís Trevizan, Júlia Fracaro, Manuela Görgen, Rudinei Fante, Emanuele Dal Pizzol, Matheus Welter, Arthur Pegoraro Klein, Thomas dos Santos Trentin, Crislaine Sartori Suzana-Milan, and Pedro Palencia. 2024. "Arbuscular Mycorrhizal Fungi, Ascophyllum nodosum, Trichoderma harzianum, and Their Combinations Influence the Phyllochron, Phenology, and Fruit Quality of Strawberry Plants" Agronomy 14, no. 4: 860. https://doi.org/10.3390/agronomy14040860
APA StyleChiomento, J. L. T., Fracaro, J., Görgen, M., Fante, R., Dal Pizzol, E., Welter, M., Klein, A. P., Trentin, T. d. S., Suzana-Milan, C. S., & Palencia, P. (2024). Arbuscular Mycorrhizal Fungi, Ascophyllum nodosum, Trichoderma harzianum, and Their Combinations Influence the Phyllochron, Phenology, and Fruit Quality of Strawberry Plants. Agronomy, 14(4), 860. https://doi.org/10.3390/agronomy14040860

